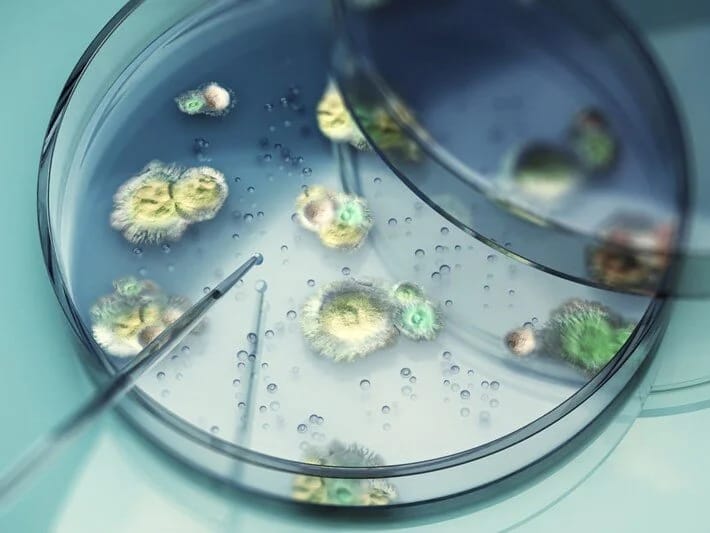
Ölümcül göbələk yayılır: Bədənə nüfuz edir, içəridən öldürür

7NEWS.az xəbər verir ki, ABŞ-da sürətlə yayılan ölümcül bir göbələk növü insan bədənini içəridən çürüdə bilər. O, ağciyərlərdən beyinə və ürəyə doğru hərəkət edir.
16 İyun 2025, 16:00
16 İyun
2025
16:00
129



























